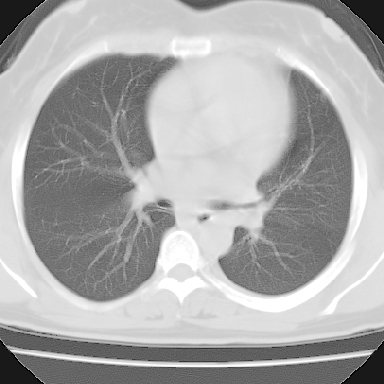
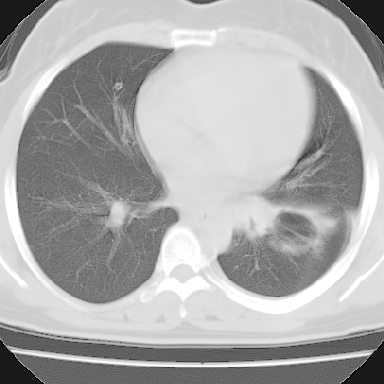
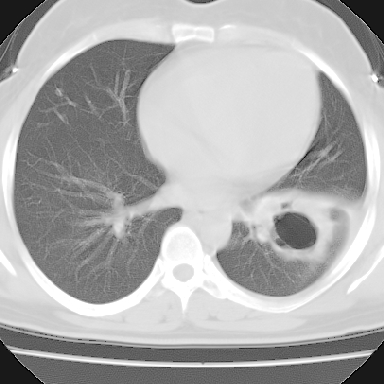

医影在线
标题: CT5487:胸部-空洞 [打印本页]
作者: glyy 时间: 2006-12-4 17:22
标题: CT5487:胸部-空洞
f 37 咳嗽1周,咯血1次,无浓痰,无明显发热

[本贴已被 jiajie 于 2006-12-4 18:18:39 修改过]
[本贴已被 jiajie 于 2006-12-4 18:30:16 修改过]
作者: dyqct 时间: 2006-12-4 17:49
标题: 肺癌伴转移
周围型空洞型肺癌伴肺转移。

[本贴已被 dyqct 于 2006-12-4 9:49:33 修改过]
作者: 清风照影来 时间: 2006-12-4 18:03
左下肺肿块影,内可以见小泡征,并见厚壁空洞形成,洞内缘凹凸不平,可见壁结节。靠近胸膜侧可见胸膜凹陷征。左侧胸腔内可见少量低密度积液影。右肺可见两处高致密的小结节影。
考虑:左下肺周围型肺癌伴右肺转移
作者: wnlyq8688 时间: 2006-12-4 18:24
标题: 回复:胸部-空洞
以下是引用dyqct在2006-12-4 9:49:00的发言:[br]周围型空洞型肺癌伴肺转移。[br]
[br][br][br][本贴已被 dyqct 于 2006-12-4 9:49:33 修改过]
偏心厚壁空洞壁结节
并右肺转移!病史肯定较长,考虑低分化磷癌可能.等待手术结果.
[本贴已被 wnlyq8688 于 2006-12-4 10:26:47 修改过]
作者: 迎客松abc 时间: 2006-12-4 18:25
左下肺肿块影,内可以见小泡征,并见厚壁空洞形成,洞内缘凹凸不平,可见壁结节。靠近胸膜侧可见胸膜凹陷征。左侧胸腔内可见少量低密度积液影。双肺可见多发性小结节影。
考虑:左下肺癌性空洞伴两肺转移
作者: 守望可可 时间: 2006-12-4 19:06
标题: 回复:胸部-空洞

作者: wz86100315 时间: 2006-12-4 19:38
支持
作者: 815989 时间: 2006-12-4 20:28
很典型哦,支持版主
作者: kbzyycm 时间: 2006-12-4 20:37
考虑:左下肺癌性空洞伴两肺转移
作者: jinguoji 时间: 2006-12-4 20:51
支持左下周围型空洞型肺癌伴两肺转移
作者: zbf1964724 时间: 2006-12-4 21:00
左下肺肿块影,内可以见小泡征,并见厚壁空洞形成,洞内缘可见壁结节。靠近胸膜侧可见胸膜肥厚粘连。双肺可见多发性小结节影。
考虑:左下空洞性肺癌伴两肺转移
作者: qyzyy-ym 时间: 2006-12-4 21:01
支持左下周围型空洞型肺癌伴两肺转移
作者: 云中漫步者 时间: 2006-12-4 21:22
支持左下肺周围型空洞型肺癌伴两肺转移。
偏心性厚壁空洞,壁结节,胸膜肥厚粘连,双肺多发性小结节灶。这么多典型征象,即使错了也错的有道理!
作者: zjzjr 时间: 2006-12-4 21:41
支持左下周围型空洞型肺癌伴两肺转移
作者: 卜一 时间: 2006-12-4 22:00
病灶与临床特点:1 位于下肺外围.2 与胸膜关系密切并明显胸膜反应.3 空洞内壁虽见壁结节,但还是较光滑.4 病灶周围明显渗出.5 另肺内多发小结节.6 临床症状轻,发病时间短.综合考虑:肺内特殊感染(霉菌感染).
作者: shenjun18 时间: 2006-12-4 22:19
支持
作者: liaoqiang 时间: 2006-12-4 22:48
支持考虑左肺下叶癌性空洞伴双肺转移。
作者: zyx168 时间: 2006-12-4 23:13
周围型肺癌并肺内转移
作者: wqs571018 时间: 2006-12-5 00:51
标题: 回复:胸部-空洞
以下是引用守望可可西里在2006-12-4 11:06:00的发言:[br]
[br]
患者毕竟年轻,结论还应慎重.
作者: duguo 时间: 2006-12-5 01:56
肺癌
作者: 宝天曼 时间: 2006-12-5 02:29
考虑:左下肺癌性空洞伴两肺转移
作者: 拾荒者 时间: 2006-12-5 02:52
标题: 回复:ct5487:胸部-空洞
以下是引用迎客松abc在2006-12-4 10:25:00的发言:[br]左下肺肿块影,内可以见小泡征,并见厚壁空洞形成,洞内缘凹凸不平,可见壁结节。靠近胸膜侧可见胸膜凹陷征。左侧胸腔内可见少量低密度积液影。双肺可见多发性小结节影。[br]考虑:左下肺癌性空洞伴两肺转移 [br] [br]
支持。另外,双侧腋下似见增大淋巴结影,有侧乳腺4、5点处皮下高密度结节影是什么?食管中下段有没有问题?病人比较年轻,因此诊断恶性肿瘤要慎重,多结合临床和其他检查,多考虑一些,也可短期抗炎治疗后复查。
作者: zcjyc001 时间: 2006-12-5 02:57
左下周围型空洞肺癌伴两肺转移
作者: zwq888 时间: 2006-12-5 03:29
左下肺有空洞,壁厚薄不均,壁结节,两肺多发小结节影,腋窝下可疑淋巴结肿大,综上所述考虑周围性肺癌并两肺转移可能性大,建议穿刺活检。
作者: jiazh 时间: 2006-12-5 03:43
右肺多发小结节影,边界清楚,符合转移瘤的特点;2、左下肺偏心性空洞影,右侧乳腺内高密度影,需要查体除外右侧乳腺肿瘤;3、腋窝淋巴结肿大,考虑转移。
作者: 李世军 时间: 2006-12-5 04:02
病灶与临床特点:1 位于下肺外围.2 与胸膜关系密切并明显胸膜反应.3 空洞内壁虽见壁结节,但还是较光滑.4 病灶周围明显渗出.5 另肺内多发小结节.6 临床症状轻,发病时间短.综合考虑:肺内特殊感染(霉菌感染).
作者: lyue2621 时间: 2006-12-5 04:07
支持癌性空洞:壁厚,无液平,内壁不规则,外壁呈分叶状,较大,偏心性,壁结节,胸膜凹陷,转移灶。
作者: 晨星剑 时间: 2006-12-5 04:42
意见;1.左下肺癌并肺转移.
2.肺结核不排除,请进一步检查.
作者: tangtianheng 时间: 2006-12-5 21:16
1、癌性空洞,右肺小结节考虑转移。2、曲霉菌感染?右侧为播散
作者: shibing 时间: 2015-7-14 15:17
左下肺肿块影,内可以见小泡征,并见厚壁空洞形成,洞内缘凹凸不平,可见壁结节。靠近胸膜侧可见胸膜凹陷征。左侧胸腔内可见少量低密度积液影。双肺可见多发性小结节影。
考虑:左下肺癌性空洞伴两肺转移
| 欢迎光临 医影在线 (http://bbs.radida.com/bbs/) |
Powered by Discuz! X3.2 |